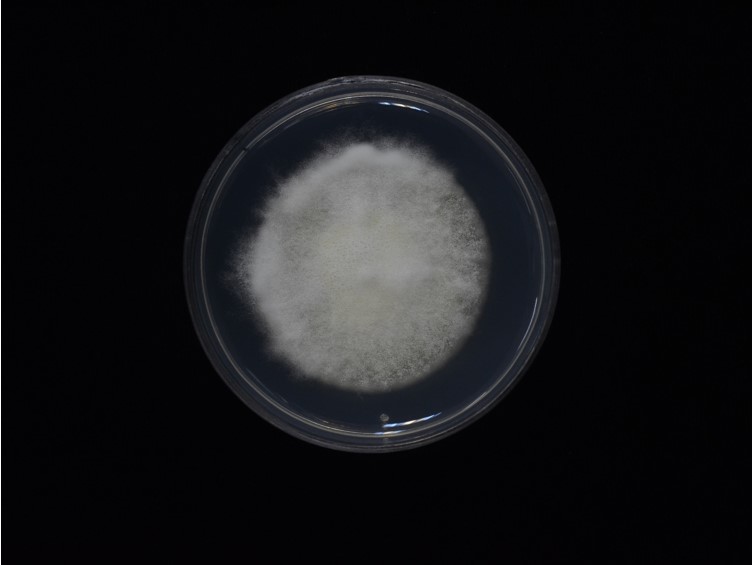

Holotype:
ITALY, Emilia-Romagna, Villa Cade, Mar. 1984, K.V. Deseo, neotype BPI 880999, ex-type living culture ARSEF 1564.
Habitat:
Leaf litters, soils, phylloplanes, occasionally from living plant tissues.
Host:
Adult beetles, click beetles, true weevils, soils.
Description:
 Hosts covered with white mycelium, powdery while sporulating.Vegetative hyphae septate, branched, hyaline, smooth-walled, 1-2 mm wide. Phialides solitary but usually in dense clusters of five or more, base subspherical to ampulliform and 3-6 mm wide, apex with an indeterminate 1 mm wide geniculate, denticulate rachis, produced laterally on aerial hyphae or from subtending cells mostly 2.5-6 3 × 3-6 mm. Conidia 2-3 × 2-3 mm, globose, subglobose or broadly ellipsoid, rarely ellipsoid, sometimes with inconspicuous hilum at base, hyaline, aseptate, walls thin and smooth.
Hosts covered with white mycelium, powdery while sporulating.Vegetative hyphae septate, branched, hyaline, smooth-walled, 1-2 mm wide. Phialides solitary but usually in dense clusters of five or more, base subspherical to ampulliform and 3-6 mm wide, apex with an indeterminate 1 mm wide geniculate, denticulate rachis, produced laterally on aerial hyphae or from subtending cells mostly 2.5-6 3 × 3-6 mm. Conidia 2-3 × 2-3 mm, globose, subglobose or broadly ellipsoid, rarely ellipsoid, sometimes with inconspicuous hilum at base, hyaline, aseptate, walls thin and smooth.
Culture characteristics:
Colony on PDA appearance densely to loosely lanose, either closely appressed to agar surface or cushion-like and up to 5 mm thick, at first white and often becoming yellowish white. Conidia aggregated as, 0.1 mm spherical clusters among aerial hyphae and white in mass15–32 mm diam at 10 d at 23 °C.
Colony on PDA appearance densely to loosely lanose, either closely appressed to agar surface or cushion-like and up to 5 mm thick, at first white and often becoming yellowish white. Conidia aggregated as, 0.1 mm spherical clusters among aerial hyphae and white in mass15–32 mm diam at 10 d at 23 °C.
Reference:
Rehner SA, Minnis AM, Sung GH, et al. (2011). Phylogeny and systematics of the anamorphic, entomopathogenic genus Beauveria Mycologia 103: 1055–1073.
DOI: https://doi.org/10.3852/10-302Species |
Strain |
Compound |
Pubchem CID |
Biological activity |
Reference |
|---|
|
Strain |
Bloc | ITS | RPB1 | RPB2 | TEF1 |
|---|---|---|---|---|---|
| ARSEF 1564 | HQ880692 | HQ880761 | HQ880833 | HQ880905 | HQ880974 |
| BCC 34332 | - | MN401655 | MN401581 | MN401605 | MN401483 |
| BCC 34338 | - | MN401656 | MN401582 | MN401606 | MN401484 |
| BCC 35939 | - | MN401665 | MN401591 | MN401613 | MN401493 |
| BCC 45145 | MN401537 | MN401667 | MN401593 | MN401615 | MN401495 |